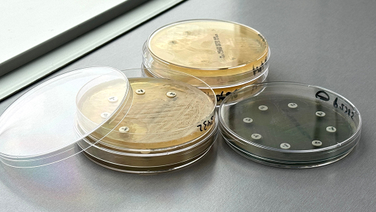

Nuevas guías ISCAID: claves para un uso responsable de antimicrobianos en pioderma canina

La pioderma en perros, una de las principales causas de prescripción antibiótica en medicina veterinaria, tiene ahora un nuevo marco clínico para su abordaje responsable.
La Sociedad Internacional de Enfermedades Infecciosas en Animales de Compañía (ISCAID) ha publicado sus guías 2025 sobre el tratamiento de la pioderma en perros, con un enfoque firme en la responsabilidad antimicrobiana.
Esta será una guida de referencia para los veterinarios, aquí te resumimos las principales novedades que incluyen.
Principales novedades y recomendaciones
1. La citología es obligatoria
Tras un examen completo de la piel y antes de administrar cualquier antimicrobiano es necesario hacerla. Debemos confirmar la infección bacteriana y nos permite orientar el tratamiento. Además, la ISCAID recomienda investigar y tratar siempre la causa subyacente del pioderma.
Respecto al cultivo y antibiograma, ¿cuándo hacerlo? Se recomienda siempre que nos hallamos ante pioderma profundo y ante pioderma superficial recurrente.
2. La terapia tópica: nuestra aliada clave
La terapia con antisépticos como clorhexidina es el tratamiento de elección para las formas superficiales y de superficie. Este enfoque permite evitar el uso innecesario de antibióticos sistémicos.
Respecto al uso de antibióticos tópicos, se recomienda sólo si la citología lo indica.
3. Antibióticos sistémicos: cuándo y cómo
Los antibióticos sistémicos deben reservarse para los casos de pioderma profunda y para piodermas superficiales que no responden a tratamiento tópico. Lo mejor siempre es evitar los antibióticos de amplio espectro sin antibiograma previo.
4. Tiempos de tratamiento
La ISCAID recomienda que los tratamientos sistémicos iniciales tengan una duración de 2 semanas en pioderma superficial y 3 semanas en pioderma profunda. Al terminar el tratamiento inicial es esencial llevar a cabo una reevaluación clínica para valorar el éxito completo del tratamiento. Esta práctica ayuda a evitar pasar por alto posibles resistencias.
5. ¿Antibióticos de primera línea?
En este punto tenemos una buena noticia, parece que los antibióticos de primera línea como cefalexina, amoxicilina-clavulánico y clindamicina siguen mostrando buena eficacia frente a Staphylococcus pseudintermedius sensible a meticilina. Estos principios activos, serán nuestra primera opción si debemos usar un antibiótico. ¡Ojo! Siempre es mejor hacer un antibiograma previo, y solo está justificada la terpaia empírica cuando el paciente presenta pioderma por primera vez y el curso es leve/moderado.
De usar otros antimicrobianos, debe hacerse siempre ante un antibiograma previo.
6. Plan B: cultivo y antibiograma
Cuando nos hallemos en presencia de resistencias o ante un fracaso terapéutico, el cultivo y antibiograma son imprescindibles para una elección racional del antibiótico.
A ser posible debemos priorizar antibióticos de primera y segunda línea y evitar fluroquinolonas y linezolid, rifampicina, vancomicina, daptomicina, tigeciclina, carbapenémicos, que están reservados para infecciones graves por multirresistentes.
7. Manejo de perros con enfermedad cutánea tópica
Se recomienda instaurar terapia tópica preventiva con antisépticos en perros con enfermedades cutáneas crónicas o predisposición a recaídas, como los que presentan dermatitis atópica o intertrigo. Esta práctica pretende evitar infecciones secundarias en estos pacientes predispuestos.
Implicaciones clínicas
Estas nuevas guías subrayan un cambio de paradigma: menos dependencia de antibióticos sistémicos, más diagnóstico preciso y manejo individualizado. Además, fortalecen el papel del veterinario como pieza clave en la lucha global contra la resistencia antimicrobiana.
Para acceder al documento completo, visita: https://onlinelibrary.wiley.com/doi/10.1111/vde.13342